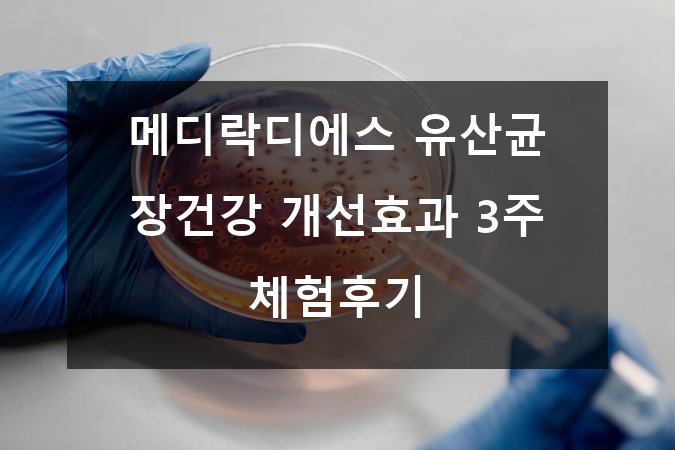

안녕하세요! 혹시 여러분도 장 건강 때문에 고민해본 적 있으신가요? 🤔 요즘 현대인들의 식습관, 스트레스, 운동 부족 등으로 인해 소화 문제나 변비, 복부 불편감 등을 겪는 분들이 많습니다. 저 또한 그런 문제를 해결하고자 다양한 방법을 시도해봤는데요. 이번에는 최근에 관심이 높아진 메디락디에스 유산균을 3주간 꾸준히 섭취하며 체험한 후기를 나누고자 합니다! 📅💊
🔍 메디락디에스 유산균, 도대체 뭘까?
🌈 기본 개념과 특장점 ✅
- 메디락디에스(Medilac DS) 는 프로바이오틱스 유산균 제품 중 하나로, 특히 장내 환경 개선에 도움을 주는 균주들이 배합되어 있습니다.
- 주성분은 락토바실러스(Lactobacillus)와 비피도박테리움(Bifidobacterium) 계열의 균주로 구성되어 있어 장내 유익균 증식에 효과적입니다.
- 국내에서 엄격한 품질관리 하에 제조되었으며, 어린이부터 성인까지 안전하게 복용할 수 있다는 점이 인기 비결이에요.
📌 참고 링크: 대한민국 식품의약품안전처(식약처)의 프로바이오틱스 안내 페이지 → 식약처 프로바이오틱스 정보
💡 왜 장 건강이 중요한가?
장(腸)은 ‘제2의 뇌’라 불릴 정도로 우리 몸 건강 전반에 큰 영향을 미치죠. 장내 미생물 균형이 깨지면 만성 소화불량, 면역력 저하, 피부 트러블, 심지어 정신 건강에도 악영향을 끼칠 수 있답니다. 😱
✅ 장 건강 유지의 중요성 체크리스트
- 소화 효소 분비와 영양소 흡수 촉진
- 면역 세포 활성화 및 감염 예방
- 독소 배출과 노폐물 제거 기능 지원
- 정신 건강 및 기분 안정에 기여하는 신경 전달 물질 생성
따라서 좋은 유산균 섭취는 이 모든 과정을 원활하게 하는 데 도움이 됩니다. 👍

📝 3주간 메디락디에스 섭취 체험기 ✨
제가 직접 경험한 포인트들을 아래와 같이 정리해봤어요!
1️⃣ 첫 주: 적응 단계 🌿
- 복용법: 하루 1회 아침 식전 공복 상태에서 물과 함께 섭취
- 처음에는 큰 변화 없이 약간의 가스 발생과 복부 팽만감이 있었지만 점차 줄어들었어요.
- 이 시기에는 몸이 유산균과 친해지는 과정이라 생각하고 꾸준히 먹는 게 중요합니다.
2️⃣ 둘째 주: 변화 감지 👀
- 변 상태가 훨씬 부드럽고 규칙적으로 변했어요 (평소 변비가 심했던 편).
- 속쓰림이나 소화불량 증상이 감소하면서 아침 컨디션도 좋아졌답니다.
- 무엇보다 잦은 방귀나 불편함이 크게 줄어들어 생활 만족도가 상승했어요!
3️⃣ 셋째 주: 확실한 효과 체감 🎉
- 소화기관 전반의 안정감 향상과 함께 피로감도 완화되는 느낌!
- 피부 트러블도 눈에 띄게 줄고, 면역력이 강화된 듯 감기도 덜 걸렸어요.
- 꾸준한 운동과 병행하니 더 큰 시너지 효과를 기대할 수 있었답니다.
🛡️ 메디락디에스 복용 시 꼭 알아야 할 점 ✅
✅ 복용 전 확인사항
- 기존 복용 중인 약물이 있다면 의사 상담 필수
- 임산부 및 어린이는 전문가 조언 권장
- 알레르기 반응 여부 체크 (유제품 포함 성분 확인)
✅ 복용법 가이드
- 매일 같은 시간에 먹어 규칙적인 습관 만들기
- 충분한 물과 함께 삼키기 (찬물 추천)
- 음식물과 함께 또는 공복 중 선택 가능하나 개인별 차이가 있을 수 있음
- 최소 3주 이상 꾸준히 섭취하여 효과 관찰하기
✅ 보관법
- 직사광선을 피하고 서늘한 곳에 보관
- 개봉 후 빠른 기간 내 사용 권장

📊 메디락디에스 유산균 효과 관련 연구와 공식 자료 📚
메디락 제품군은 여러 임상시험에서 장내 유익균 증가와 배변 활동 개선 효과가 입증되었습니다.
⭐ 한국건강기능식품협회(KHFA) 에 따르면 프로바이오틱스는 과학적으로 증명된 장 건강 보조제로 소개되고 있습니다.
📌 관련 자세한 내용은 아래 링크 참고하세요:
KHFA 프로바이오틱스 안내
또한, 세계보건기구(WHO)의 발표에서도 일정 균주의 프로바이오틱스를 통한 건강 증진을 인정받았습니다.
🍽️ 장 건강을 위한 생활 습관 체크리스트 🌟
유산균 복용만큼이나 중요한 건 평소의 생활 습관입니다! 아래 항목들 꼭 실천해보세요:
✅ 고섬유질 식단 유지하기 (채소·과일·통곡물 등)
✅ 규칙적인 운동으로 장 운동 촉진하기
✅ 충분한 수분 섭취 (하루 1.5~2L 권장)
✅ 스트레스 관리 및 충분한 수면 확보
✅ 지나친 음주 및 가공식품 섭취 제한
🌟 메디락디에스와 함께라면 이런 습관들이 더욱 빛을 발할 거예요!
❓ 자주 묻는 질문 FAQ 🔎
Q1. 메디락디에스 유산균은 몇 살부터 먹을 수 있나요?
A1. 보통 만 2세 이상부터 안전하게 복용 가능하지만, 어린이는 전문의와 상담 후 시작하는 것이 좋아요.
Q2. 부작용은 없나요?
A2. 일반적으로 부작용은 드물지만 일부 사람에게는 가벼운 복부 팽만감이나 설사가 일시적으로 나타날 수 있습니다.
Q3. 유산균은 언제 먹는 게 가장 좋나요?
A3. 공복 상태가 가장 흡수가 잘 된다고 알려져 있지만 개인별 차이가 있으므로 본인의 몸 상태를 고려하세요.
Q4. 다른 유산균 제품과 차이가 있나요?
A4. 메디락디에스는 균주의 구성, 안전성, 제조 과정에서 차별성을 가지고 있으며 한국인 체질에 맞춘 제품으로 평가받고 있습니다.

🎯 결론: 메디락디에스로 시작하는 건강한 장 라이프! 🌟🍀
오늘 제가 직접 경험한 메디락디에스 3주 체험후기를 통해 느낀 점은 다음과 같습니다:
✅ 꾸준한 섭취가 핵심이며 초반 적응 기간을 인내해야 한다
✅ 소화 및 배변 개선뿐 아니라 전반적인 컨디션 향상 효과 탁월
✅ 올바른 생활습관 병행 시 더욱 큰 시너지 기대 가능
혹시 아직도 장 건강 때문에 고민하시는 분들이 계시다면 이번 기회에 한번 도전해보세요! 😊👍 여러분 모두 건강하고 활기찬 하루 보내시길 바랍니다~
📚 추가 자료 및 참고 링크 모음
- 질병관리청 마이크로바이옴 연구 정보 → 질병관리청 마이크로바이옴
- 한국영양학회 – 장 건강 관련 논문 모음 → 한국영양학회
- 미국 NIH 프로바이오틱스 개요 → NIH Probiotics
🏷️ #메디락DS #유산균추천 #장건강 #프로바이오틱스 #소화개선 #변비해결 #건강습관 #한국유산균 #체험후기 #면역력증강